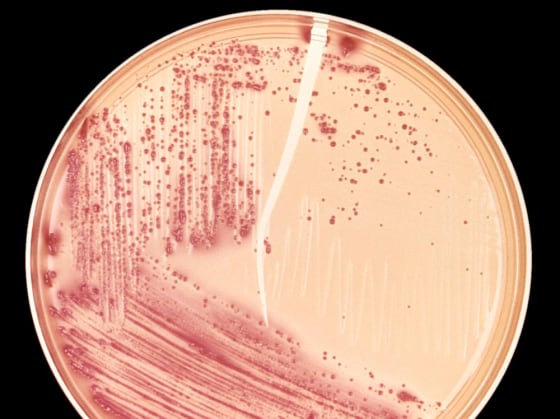
Image: E. coli in a petri dish

Just as humans have learned to connect dark clouds with rain, so too have bacteria and yeast learned to use one event to predict the arrival of another.
"For multicellular organisms, there is a real benefit to understanding the temporal order of things," said Amir Mitchell, a scientist at The Weizmann Institute of Science in Israel and co-author of a paper that appeared recently in the journal Nature. "If you see clouds you might expect rain, and take an umbrella out with you."
The two organisms studied in the research, Escherichia coli and fermenting yeast, Saccharomyces cerevisiae, are widely used by humans for very different reasons. E. coli can travel through the human digestive tract. Winemakers have used yeast to turn sugar into alcohol for thousands of years.
In the human digestive tract, sugar lactose is present before sugar maltose. Introducing E. coli to lactose not only triggers genes that let the bacteria metabolize lactose, but also initiates the expression of genes that produce enzymes that can metabolize maltose. No maltose is yet present, but the bacteria are now equipped to metabolize maltose when they are exposed to it.
In wine bottles, yeast must withstand the heat produced during fermentation and then the chemical pressure of oxidation. As the bottles heat up, the yeast activate genes that allow them to survive the heat. This also triggers the activation of genes that enable the yeast to survive oxidation, the next stage of the fermentation process.